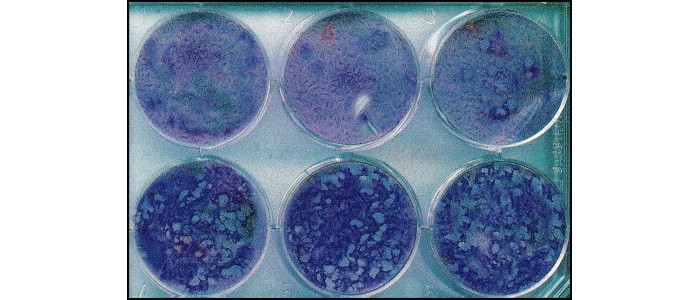
Вакцина проти деменції цілком може вже існувати

Згідно з недавнім дослідженням, проведеним Стенфордським університетом у США, вакцина проти оперізувального герпесу може знизити ризик розвитку деменції на 20 відсотків або сповільнити прогрес захворювання після перенесеної вакцинації.
Якщо ці результати підтвердяться в майбутніх дослідженнях, вакцина, яка вже доступна, може бути використана для профілактики та лікування деменції: невиліковного захворювання, на яке, за оцінками, страждають 57 мільйонів людей у всьому світі.
У дослідженні, опублікованому в журналі Nature, вчені проаналізували медичні карти понад 280 тисяч дорослих жителів Уельсу віком від 71 до 88 років. Їхньою метою було зрозуміти ефект програми вакцинації проти оперізувального герпесу, що розпочалася у 2013 році.
Вони виявили, що у людей похилого віку (віком 79–80 років), які отримали вакцину проти оперізувального герпесу, ймовірність розвитку деменції до 2020 року була на 20 відсотків нижчою порівняно з тими, які не були вакциновані.
Провідний автор дослідження, доцент кафедри медицини Стенфордського університету доктор Паскаль Гельдсетцер, назвав це «дійсно вражальним відкриттям», додавши: «Цей потужний захисний сигнал був присутній, з якого б боку ви не дивилися на дані».
Щобільше, в недавньому подальшому дослідженні, опублікованому в журналі Cell, ті ж учені виявили, що вакцина проти оперізувального герпесу, мабуть, чинить захисну дію навіть серед тих, у кого деменція була діагностована до 2013 року.
З 7049 дорослих жителів Уельсу, які брали участь у дослідженні та страждали на деменцію, майже половина померла протягом наступних дев'яти років. Але серед тих, хто отримав вакцину проти оперізувального герпесу, померло лише 30 відсотків.
«Найцікавіше те, що це дійсно говорить про те, що вакцина проти оперізувального герпесу має не тільки профілактичний ефект, що сповільнює розвиток деменції, а й терапевтичний потенціал для тих, у кого деменція вже є», — сказав Гельдсетцер.
Попередні дослідження вже вказували на потенційний зв'язок між вакциною проти оперізувального герпесу та захистом від деменції, але всі вони були ослаблені тим фактом, що вакциновані люди, як правило, ведуть здоровіший спосіб життя в цілому (отже, їх захист від деменції міг бути зумовлений іншими факторами).
Однак у цьому дослідженні ця упередженість не становила такої проблеми. Це пов'язано з тим, що програма вакцинації була доступна лише певній групі людей: тим, кому на 1 вересня 2013 року виповнилося 79 років.
"Ми знаємо, що якщо взяти тисячу людей, які випадково народилися протягом одного тижня, і тисячу людей, які випадково народилися на тиждень пізніше, то в середньому між ними не повинно бути ніяких відмінностей", - сказав Гельдсетцер. "Вони схожі один на одного, за винятком цієї крихітної різниці у віці".
Іншими словами: вчені могли безпосередньо порівняти дві групи з однаковим середнім співвідношенням людей, які більш-менш дбають про своє здоров'я, які народилися з різницею всього на тиждень. Єдина різниця між ними полягала у можливості отримати цю вакцину, що значно спростило виявлення її ефективності проти деменції.
Оперізувальний герпес - це інфекція, що викликається вірусом Varicella zoster - збудником вітряної віспи. Симптоми включають хворобливе висипання, печіння або поколювання, головний біль, лихоманку і втому.
Вірус вражає нервову систему, але вчені поки точно не знають, як вакцина проти оперізувального герпесу може захистити мозок від когнітивних порушень.